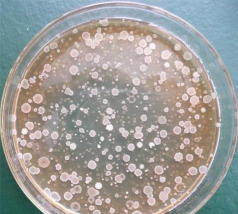

纳豆芽孢杆菌养花
纳豆芽孢杆菌是一种常见的土壤微生物,具有改善土壤结构、促进植物根系发育、提高植物抗病能力等作用。在养花过程中,可以将纳豆芽孢杆菌用于土壤改良或作为生物肥料,以提高植物的生长效果。以下是具体的应用方式:
1. 土壤改良与培肥
- 方法:将纳豆芽孢杆菌制剂均匀撒入土壤中,可改善土壤的透气性和保水性,促进土壤微生物群落的多样化。
- 适用场景:适用于贫瘠土壤、板结土壤或长期未使用土壤。
2. 生物肥料
- 方法:将纳豆芽孢杆菌与有机肥、化肥混合使用,作为生物肥料施入土壤。
- 适用场景:适用于蔬菜、花卉、果树等植物的基肥或追肥。
3. 植物根系促生
- 方法:在播种前或幼苗期,将纳豆芽孢杆菌制剂与基质混合,促进根系生长,增强植物抗逆性。
- 适用场景:适用于花卉、蔬菜、草本植物等。
4. 病害防治
- 方法:纳豆芽孢杆菌具有拮抗病原菌的能力,可用于防治土传病害,如猝倒病、根腐病等。
- 适用场景:适用于病害多发的植物,如玫瑰、番茄、黄瓜等。
其他注意事项
- 使用方法:根据产品说明,一般建议每亩施用100-500克,或按植物生长阶段适量使用。
- 使用时间:通常在种植前或生长中后期使用,效果更佳。
- 搭配使用:可配合有机肥、腐熟的堆肥等,提高肥料利用率。
如需更具体的使用建议,可提供植物种类或种植环境,我将为您进一步解答。
黄纸壳能养花吗
黄纸壳通常是指用纸制作的容器,如纸盒、纸箱等。在农业中,纸壳是否可以用来养花,主要取决于其材质、厚度和用途。以下是几种常见情况的分析:优点:纸壳轻便、成本低,适合用于小型盆栽或装饰性花卉。缺点:纸壳透水性和透气性较差,容易积水,导致根部腐烂
· 2025-11-24
养花种菜标签牌
1. 标签牌的作用标签牌是用于标识植物或菜地的标识工具,主要作用包括:区分不同植物或菜地:帮助识别不同种类的植物或菜地,避免混淆。记录种植信息:如种植时间、品种、养护方法等。便于管理:帮助农民或园丁快速找到特定区域,提高管理效率。2. 标签
· 2025-11-24
复式房子怎么养花
复式房子由于空间布局特殊,适合种植一些紧凑、易管理的花卉。以下是复式房子养花的常见做法和建议:多肉植物:如仙人掌、芦荟、小多肉等,适应性强,光照需求少,适合复式房子的光照条件。绿植:如吊兰、常春藤、虎尾兰、龟背竹等,耐阴耐旱,适合室内养护。
· 2025-11-24
松土花肥养花通用肥料
在养花过程中,松土和施肥是两个非常重要的环节。松土有助于促进根系发育、改善土壤通气性和排水性,而施肥则提供植物所需的养分。以下是一些通用的松土与施肥方法,适用于大多数花卉和蔬菜种植:定期松土 每月或每季度进行一次松土,深度一般为2-5厘米
· 2025-11-24
大型养花花盆尺寸
H3: 大型养花花盆尺寸大型养花花盆的尺寸通常根据植物的大小和生长需求来选择。以下是一些常见的大型花盆尺寸参考:小型大型花盆:通常为30-40厘米直径,适合小型盆栽植物,如多肉、薄荷、绿萝等。中型大型花盆:直径约为40-50厘米,适合中等大
· 2025-11-24
新家搬进去养花好吗
在新家搬进去后,养花是一个不错的选择,既能美化环境,又能带来愉悦的心情。以下是几点建议,帮助你更好地在新家养花:室内植物:适合室内养护的植物有绿萝、吊兰、仙人掌、芦荟、蕨类植物等。这些植物对光照和水分要求较低,适合新手。多肉植物:如多肉、仙
· 2025-11-24
养花驱赶小飞虫方法
1. 使用黄色粘虫板黄色粘虫板是防治小飞虫的有效方法之一。小飞虫对黄色有较强趋性,粘虫板可以有效捕捉飞虫,减少虫害。2. 使用驱虫剂市面上有专门的驱虫剂,如辣椒水、薄荷水、大蒜水等,这些天然物质具有驱虫效果。可将这些液体喷洒在花盆周围或植物
· 2025-11-24
客厅护栏围挡养花好吗
客厅护栏围挡养花在理论上是可行的,但需要考虑实际操作中的可行性与安全性。以下是具体分析:优点:护栏围挡通常为坚固结构,可防止植物生长过快或被风吹倒,适合种植一些耐修剪的植物,如多肉、绿篱等。缺点:若护栏较矮或未固定牢固,可能影响植物生长,甚
· 2025-11-24
养花尿素浓度多少合适
尿素是一种常用的氮肥,常用于花卉和植物的施肥中,以提供植物所需的氮元素。在养花时,尿素的浓度通常根据植物种类、生长阶段以及土壤状况进行调整。一般家庭花卉:通常使用1%-2%的尿素浓度进行施肥,适合多数花卉的生长需求。生长旺盛的植物:可适当提
· 2025-11-24
养花人出门捡垃圾
养花人出门捡垃圾是一种环保行为,但需要注意以下几点,以确保不影响植物和周围环境:不要在花盆周围乱扔垃圾:尤其是塑料袋、纸张等易造成土壤污染的物品,可能损坏植物根系或土壤结构。避免使用有害垃圾:如电池、塑料制品等,这些物品可能对植物造成毒害。
· 2025-11-24